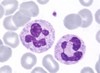
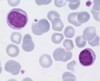
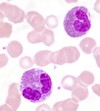
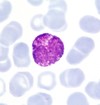
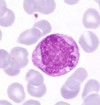

Week 2 Flashcards
(85 cards)
Where are the peripheral chemoreceptors? What do they do?
aortic bodies on the arch of the aorta
carotid bodies on the carotid sinus
Sense tension of O2, CO2 and H+ in blood.
Name some autoimmune causes of interstitial lung disease
- Wegener’s
- Churg-Strauss
- Systemic Lupus Erthyematosus
- Bechet’s
COPD clinical syndrome - symptoms
chronic, not episodic associated with smoking daily productive cough progressive breathlessness frequent infective exacerbations CB - wheezing Emphysema - reduced breath sounds
What is the target of muscarinic receptor antagonist drugs? I.e. SAMAs, LAMAs (give examples of both)
M3 receptor on smooth muscle
SAMA - ipratropium (non-selective), oxitropium
LAMA - tiotropium, aclinidium
Treatment of stable COPD
Dependent on GOLD staging. A - SAMA/SABA B - LAMA C - LABA/LAMA or ICS/LABA D - ICS/LABA/LAMA (C and D are dependent on 2 or more exacerbations per year)
Name that cell!
Neutrophil, single multi-lobed nucleus
Increase in
- stress, both physiological and pathological (acute infection, trauma, infarction, inflammation)
- steroids, causes ‘de-margination’
How is stimulation of the dorsal neurones terminated?
Pneumotaxic centre (PC), located superiorly to the dorsal neurones gets excited by dorsal firing and inhibits inspiration. Without the PC, breathing would be prolonged, with lots of inspiratory gasps and brief expirations
Where are M3 receptors found? What do they do?
Smooth muscle
Mediate contraction to ACh. Also present on mucous-producing cells and evoke increased secretion

Which ILD is erythema nodosum associated with?
Sarcoidosis
Briefly outline the asthma treatment pyramid?
(bottom to top)
- Reliever - SABA
- Preventer - ICS
- Controller (2nd line additive to ICS) - theophylline, LTRA, LABA/LAMA
- Controller - oral steroid

When are tests most useful with regards to prevalence measure?
When prevalence is at 50%
What Clotting factors are involved in Prothrombin Time (PT)?
II, V, VII and X
How is COPD severity assessed?
GOLD staging, management is dependent on this.
What clotting factors are involved in Activated Partial Thromboplastin Time (aPTT)?
II, V, VIII, IX, X, XI and XII
What external influences are there on the respiratory centres responsible for breathing rhythm?
Higher brain centres
Stretch receptors in the walls of bronchi and bronchioles, guards against hyperinflation (Hering-Breur reflex)
Juxtapulmonary receptors - stimulated by pulmonary capillary congestion and pulmonary oedema i.e. heart failure
Joint receptors - impulses from moving limbs increases breathing
Baroreceptors
Central and peripheral chemoreceptors - sense the values of gas tensions, example of negative feedback control
Respiratory acidosis
Increasing [H+] due to increasing pCO2
[H+] is proportional to pCO2/[HCO3-], so HCO3- will also have to rise to compensate, kidneys excrete extra [H+] (occurs slowly)
What is the best drug combination for treating someone with moderate COPD?
Combo of LABA and LAMA, superior to either drug alone at increasing FEV1.
These drugs work in different but complimentary ways to one another to cause smooth muscle relaxation
What do alveolar macrophages release in response to cigarette smoke in patients with COPD? What is then released next?
- neutrophil chemotactic factors
- cytokines (IL-8)
- mediators (Leukotriene B4)
- TNF alpha oxygen radicals.
Proteases (collagenase, elastase) released by neutrophils, causing mucous hypersecretion in chronic bronchitis or alveolar wall destruction in emphysema.

What is pneumoconiosis? Give some causes
Another ILD, a “mineral dust disease” Causes are fibrogenic and non-fibrogenic. Fibrogenic - asbestosis, silicosis Non-fibrogenic - siderosis (iron), stanosis (tin), baritosis (barium)
What’s the difference between -aemia and -osis? I.e. acidaemia and acidosis
Acid/Alkalaemia is referring to an increase or decrease in [H+]
Acid/alkalosis is referring to the process tending to cause an increase or decrease in [H+]
Where are M1 muscarinic receptors found? What do they do?
Ganglia
Facilitate fast transmission mediated by ACh acting on nicotinic receptors

How does the body compensate in the case of…
- excess H+
- excess CO2
- too much H+, body blows out more CO2
- too much CO2, body excretes H+ via the kidneys
H+ + HCO3- ⇔ H2CO3 ⇔ CO2 + H2O
Describe developing red cells - where do they develop, what do they contain and what do they require?
- Where? Bone marrow
- Contain? A nucleus, unlike matured RBCs
- Require? Vitamin B12 and folate for the nucleus to mature before its removal
What groups of neurones are involved in active expiration?
VENTRAL neurones get excited during increased firing of dorsal neurones. Go on to excite internal intercostal and abdominal muscles, leading to forceful expiration.